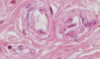

Coupes pour observer les différents types de vx:



Structure pointée = Nerfs ÉNORME (circule à côté de l’artère)
==> Bien délimitée, régions blanches avec ptt point au milieu, noyaux entre les structures
NB: (sur la coupe violette: Transition progressiveentre artère purement élastique et artère musculaire)


K’

A = veine (paroi mince pas régulière)
=> JAMAIS de GR ds vx lymphatique!!!
B= artère (paroi compacte, homogène et épaisse par rapport au diamètre)
C = artère
D = vx lymphatique (paroi très mince présence de leucocytes mais pas GR)
E = lymphatique (paroi très mince + endothélium et aspect granulaire rosé (lymphe))
Quelle est la couche la plus importante dans une artère?
Média
(le critère qui permet de distinguer l’artère des veines)
Est-ce qu’on peut bien voir la lame élastique au niv de la média en hémalun éosine?
Pas vraiment
(parfois on peut bien distinguer la lame élastique interne si épaisse mais le reste c chaud, car colorées en rose et se confondent avec cytoplasme ce cell muscu lisses car contiennent des prot)
C’est-ce quoi la partie brillante sur cette photo?

Lame élastique externe, très ramifiée (c rare qu’on puisse la voir en hémalin éosine)
Ça c quoi?

Artère
==> Partie plus mince = bifurcation en une artère plus petite (mais c tjrs une artère parce qu’on voit la paroi compactes et homogène)
Ça c quoi?

Nerfs, ça se voit
C quoi?

PAS UN VAISSEAUX CAR LA 1ÈRE COUCHE N’EST PAS UN ENDOTHÉLIUM SIMPLE APPLATI!!!
(au début on peut se dire que c une artère parce que bcp de muscuature mais 1er critère = présence d’un endothélium)
Quel épithélium?

Psoeudo-stratifié
=> Cell prismatiques
Cell basales
et pas ttes les cell prismatiques touchent la lame basales (≠ bistratifié)
=> Stéréocils à la surface (pas à savoir reconnaître) ===> canal déférent (syst génital masculin = seul endroit avec stéréocils)
Quoi comme vx?

Artère (même si elle est pas ronde)
=> Musculature compacte et homogène sur tout le pourtour
Est-ce qu’on peut affirmer que dans tout les cas:
- les artères sont rondes
- les veines sont plus biscornues
NON!!!!!!!!!!!
Artère pas formcément ronde!!
Veine pas tjrs avec des formes chelou!!!
Quand on a un doute sur le vx, en général c quoi?
Une veine
=> Parce que pour artère en général y a pas de doute, c évident donc par défaut, si y’ a un doute, c une veine
Là c quoi?

Veine
=> Car paroi pas homogène et pas bien délimitée
=> MUSCULAIRE car bcp de musculature dans la média (on voit la différence ente la média et d’adventice car muscu coupée transversalement dans la média et longitudinalement dans l’adventice mais c pas super évident)
C quoi ce tissu?

Muscle strié squelettique (coupé transversalement)
=> Cell grandes
=> Plsrs noyaux par cellules
=> Noyaux en périphérie
=> Cytoplasme bien coloré (actine + myosine 2)
Quel épithélium?

Simple prismatique avec des kinocils
(mais bon quelques zones un peu ambiguës)
C quoi?

Veine
Quel vx?

Artère (certes, biscornue)
=> On voit bien la limite de la média et de l’adventice
=> Épaisseur régulière, compacte, homogène sur tout le porutour
Quel vx?

Artère
Quel vx?

Veine
=> Paroi fine et pas du tt régulière

Ça?

Artère
Ça aussi d’ailleurs…